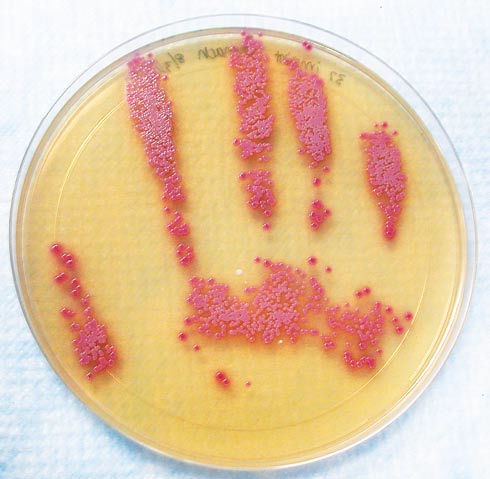

Sometimes our discussion of infection control become somewhat theoretical, we talk about frequencies and methodologies. Here are a sequence of images that are worth a thousand words. the first 2 are from a publication in the New England Journal of Medicine
Donskey CJ, Eckstein BC: The Hands Give It Away. New England Journal of Medicine 2009, 360(3):e3. http://www.nejm.org/doi/full/10.1056/NEJMicm0707259
Which shows the hand prints of a health care worker who had just palpated the abdomen of a patient. The pink colonies are Staphylococcus. the second image is after hand-washing.
Below is the story of a parent, taken from the ‘Perinatal Quality Collaborative of North Carolina’ http://www.pqcnc.org/?q=node/12878 It is a very eloquent tale of the human costs of nosocomial infections.
I have sought and received permission for the reuse of these items.